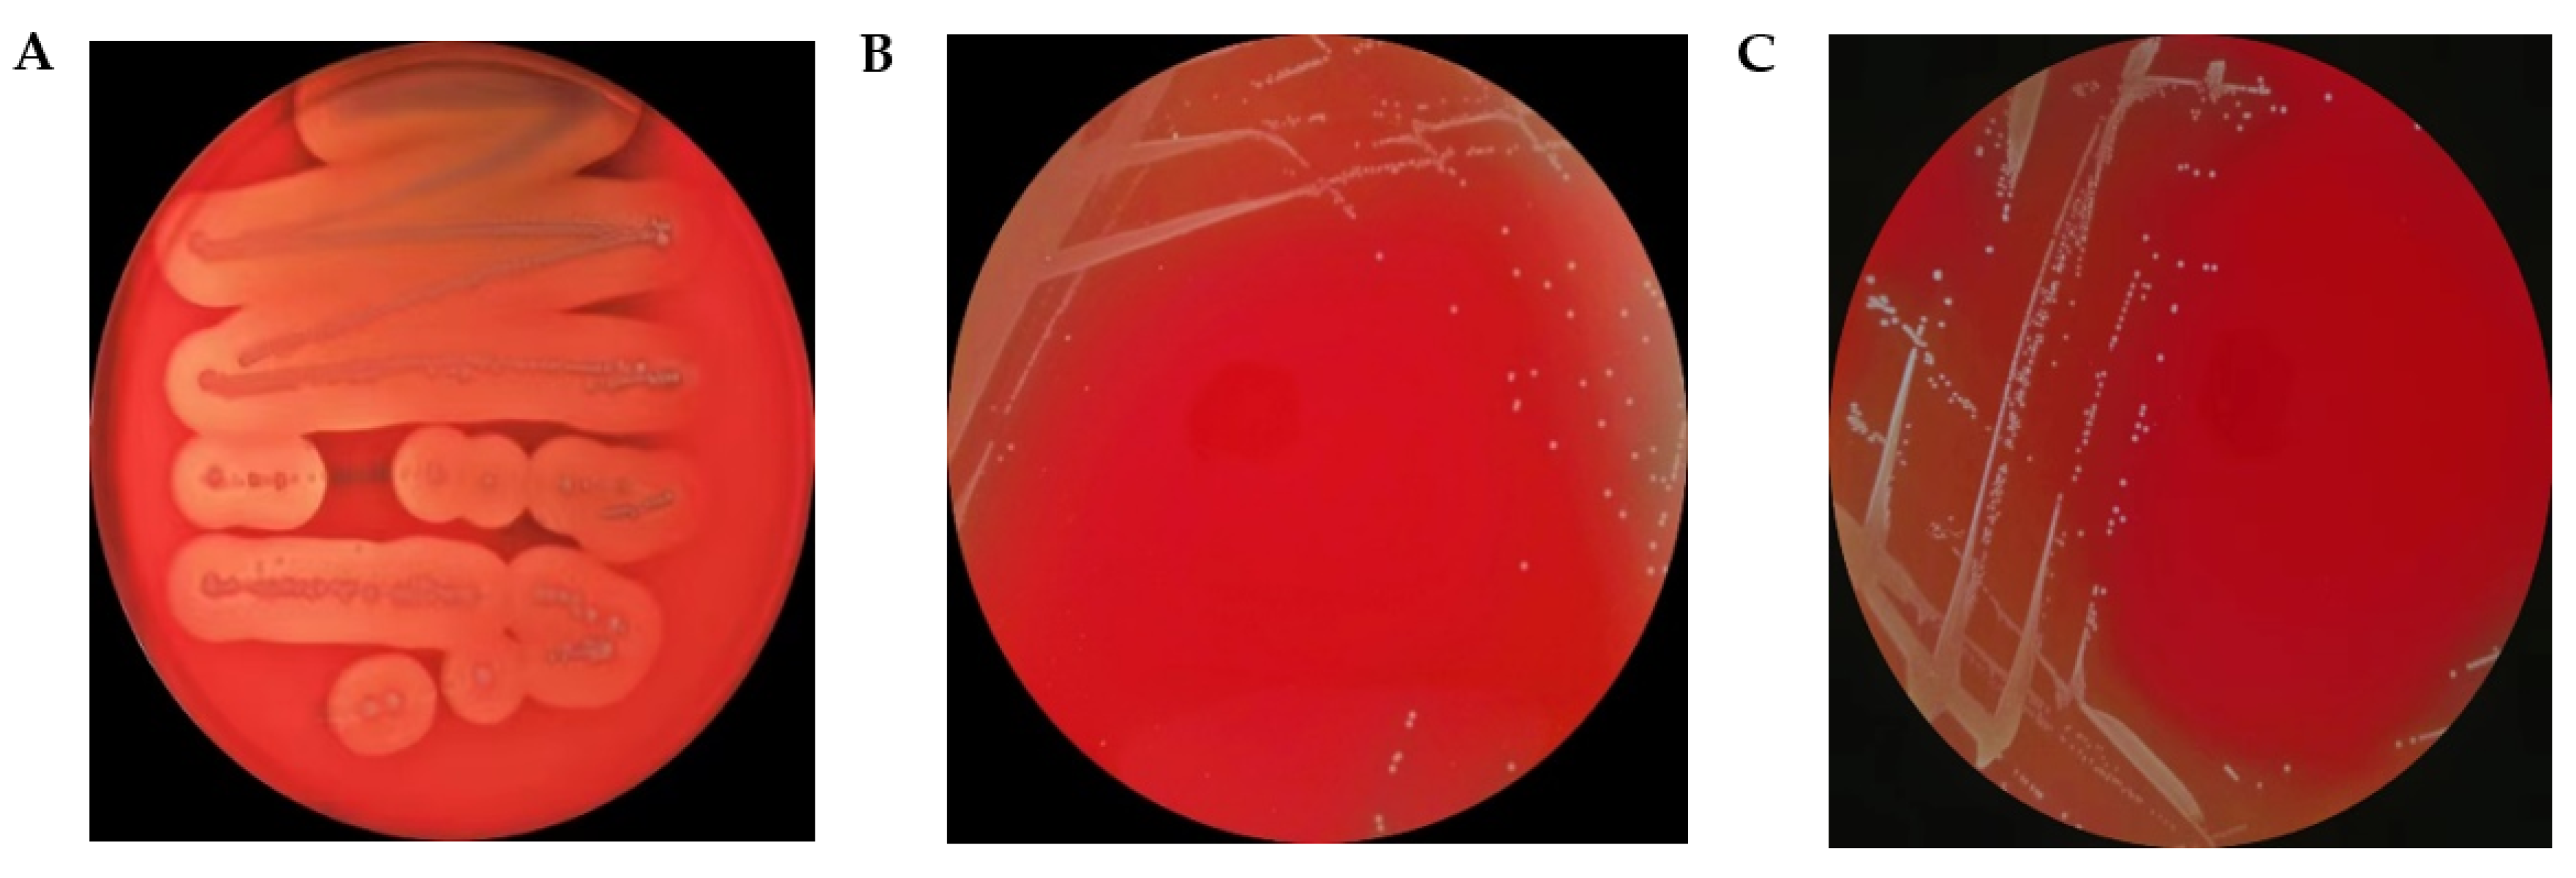
Microorganisms 11 01620 g002 Microorganisms 11 01620 g002

Abstract
This study aims to systematically evaluate the safety of a novel L. plantarum LPJZ-658 explored on whole-genome sequence analysis, safety, and probiotic properties assessment. Whole genome sequencing results demonstrated that L. plantarum LPJZ-658 consists of 3.26 Mbp with a GC content of 44.83%. A total of 3254 putative ORFs were identified. Of note, a putative bile saline hydrolase (BSH) (identity 70.4%) was found in its genome. In addition, the secondary metabolites were analyzed, and one secondary metabolite gene cluster was predicted to consist of 51 genes, which verified its safety and probiotic properties at the genome level. Additionally, L. plantarum LPJZ-658 exhibited non-toxic and non-hemolytic activity and was susceptible to various tested antibiotics, indicating that L. plantarum LPJZ-658 was safe for consumption. Moreover, the probiotic properties tests confirm that L. plantarum LPJZ-658 also exhibits tolerance to acid and bile salts, preferably hydrophobicity and auto-aggregation, and excellent antimicrobial activity against both Gram-positive and Gram-negative gastrointestinal pathogens. In conclusion, this study confirmed the safety and probiotic properties of L. plantarum LPJZ-658, suggesting it can be used as a potential probiotic candidate for human and animal applications.
1. Introduction
Probiotics have a long history of use. They have gained global consensus for their health-regulating effects, driving the rapid development of the probiotic industry. L. plantarum has one of the largest genomes known among the lactic acid bacteria (LAB) and is a facultative heterofermentative LAB [1]. It may obtain energy from different sugars, and it reflects high adaptability to a variety of niches such as dairy products, vegetables, wine, and the gastrointestinal of humans and animals [2]. Among them, L. plantarum has good physiological properties and probiotic functions and has become a hot spot for research. A large number of studies have confirmed that L. plantarum has probiotic effects such as antioxidant, dyslipidemia regulation [3], intestinal inflammation and barrier function improvement [4,5], and intestinal homeostasis regulation [6]. In addition, L. plantarum strains are capable of producing various antimicrobial compounds, such as organic acids, hydrogen peroxide, and antiaflatoxigenic [7,8], to against a wide range of pathogenic bacteria [9,10].
On the other hand, the excellent properties of L. plantarum, such as its tolerance to acidic pH [11], resistance to the gastrointestinal tract [12], and adhesion to the intestinal mucosa [13], have also made L. plantarum can have beneficial effects on the host health. Furthermore, the connection between humans and L. plantarum has been further strengthened by altering the brain parameters and host immunity. Thus, L. plantarum can be used to prevent or treat certain allergic [14], depressive [15], and Alzheimer’s disease [16], as a potential therapy for neurological and psychological disorders [17], with great potential for application development.
Although few adverse events or safety issues has been reported, the potential safety issues of probiotic still attract concern. In 2001, an expert consultation convened under the auspices of the World Health Organization (WHO) and the Food and Agriculture Organization (FAO) proposed a beneficial definition of probiotics. Later in 2014, the definition was refined to “live microorganisms that, when administered in adequate amounts, confer a health benefit on the host” and further stated that all probiotics must be “safe for their intended use [18,19,20]”. Furthermore, probiotics can survive and proliferate in the gastrointestinal tract and have a strong internal transfer capacity [21], so the development of new probiotic strains must be evaluated for safety before use. In this study, the novel L. plantarum LPJZ-658 isolated and screened from naturally fermented dairy products was evaluated, and the safety of the L. plantarum LPJZ-658 was evaluated by genome sequencing, hemolysis test, drug resistance test, and acute oral toxicity test. In addition, the probiotic properties of the L. plantarum LPJZ-658 were evaluated by tolerance test to acid and bile salt conditions, antibacterial test, hydrophobicity, and auto-aggregation test, aiming to provide a theoretical basis for the development of new functional probiotic products.
2. Materials and Methods
2.1. Bacterial Strain
L. plantarum LPJZ-658 was isolated from naturally fermented dairy products. The genome has been sequenced and submitted to the NCBI database (NCBI no. SRR22306760). Lactobacillus rhamnosus GG (LGG) was purchased from American Type Culture Collection (ATCC, 53103, St. Cloud, MN, USA). Salmonella typhimurium (S. typhimurium, BNCC333565), Escherichia coli (E. coli, BNCC269342), and Staphylococcus aureus subsp. aureus Rosenbach (S. aureus, BNCC310011) was purchased from BeNa Culture Collection, Beijing, China. L. plantarum LPJZ-658 and LGG were cultured in de Man-Rogosa-Sharpe (MRS) broth (Beijing Solarbio Science & Technology Co., Ltd., Beijing, China). S. typhimurium and E. coli were cultured in Lysogeny broth (LB) broth (Sangon Biotech Shanghai Co., Ltd., Shanghai, China). S. aureus was cultured in Brian Heart Infusion (BHI) broth (Qingdao Hi-Tech Industrial Park Hope Bio-Technology Co., Ltd., Qingdao, China). All the cultures were grown in broth overnight at 37 °C before use.
2.2. Genome Sequencing and Bioinformatics Analysis of L. plantarum LPJZ-658
The genomic DNA of L. plantarum LPJZ-658 was extracted with the SDS method [22], and the whole genome of L. plantarum LPJZ-658 was sequenced using Illumina NovaSeq PE150 at the Beijing Novogene Bioinformatics Technology Co., Ltd. (Beijing, China) and assembled with SOAPdenovo and SPAdes and ABySS software. Coding gene were predicted using GeneMarkS software (V4.17) (http://topaz.gatech.edu/GeneMark/) (accessed on 25 March 2020) [23]; repetitive sequences were predicted using RepeatMasker (Version open-4.0.5) software and TRF (Tandem Repeats Finder, V4.07b) [24,25]; transfer RNA (tRNA) prediction by tRNAscan-SE software (V1.3.1) [26], ribosomal RNA (rRNA) prediction by RNAmmer software (V1.2) [27], and small RNA (sRNA) determination by the program “cmsearch” (V1.1rc4) [28,29].
The Gene function was predicted based on seven databases, including Non-Redundant Protein Database (NR) [30], Clusters of Orthologous Groups (COG) [31], Kyoto Encyclopedia of Genes and Genomes (KEGG) [32,33], Gene Ontology (GO) [34], Transporter Classification Database (TCDB) [35], and Swiss-Prot [36]. The SignalP [37] database was used to predict the secretory proteins, while the EffectiveT3 [38] software was used to predict the Type I-VII proteins secreted by the pathogenic bacteria. Meanwhile, the secondary metabolism gene clusters were predicted by the antiSMASH [39]. Additionally, the pathogenicity and drug resistance analyses were performed by Antibiotic Resistance Genes Database (ARDB) [40], Virulence Factors of Pathogenic Bacteria (VFDB) [41], and Pathogen Host Interactions (PHI) [42]. Active enzymes involved in carbohydrate metabolism were predicted by Carbohydrate-Active Enzymes (CAZy) Database [43].
2.3. Evolutionary Analysis
The Basic Local Alignment Search Tool (BLAST) of the GenBank (NCBI) was used to determine similarity values. To indicate species identification, sequences with ≥97% similarity to the previously published sequences were utilized as the criterion. Based on the 16S rRNA gene sequence analysis, a phylogenetic tree was constructed. The analysis included 20 nucleotide sequences, including 1 sequence of Lactobacillus strains obtained in this study and 19 sequences belonging to Lactobacillus species obtained from the GenBank. The Neighbour-Joining method was used to generate evolutionary history in Molecular Evolutionary Genetics Analysis (MEGA) 11 software. Bootstrapping was confided for 1000 replicates, and only bootstrap values above 50% were shown.
2.4. Safety Test of L. plantarum LPJZ-658
2.4.1. Hemolytic Activity of L. plantarum LPJZ-658
The hemolytic activity of L. plantarum LPJZ-658 was detected as previously described with some modification [44]. L. plantarum LPJZ-658 was streaked onto a Columbia blood agar plate (Beijing Land Bridge Technology Co., Ltd., Beijing, China) and incubator at 37 °C for 48 h, the hemolysis of the colony of L. plantarum LPJZ-658 was observed based on the zone of hemolysis around the colonies. The β-hemolytic S. aureus and the γ-hemolytic LGG [45] were used as control strains.
2.4.2. Antibiotic Susceptibility of L. plantarum LPJZ-658
The antibiotic susceptibility of L. plantarum LPJZ-658 was detected using a disk diffusion method recommended by the Clinical and Laboratory Standard Institute (CLSI) [46]. Briefly, the overnight grown culture of L. plantarum LPJZ-658 was evenly coated on the MRS broth and incubated for 20 h at 37 °C. A total of 100 μL of the bacterial solution was evenly streaked onto MRS agar plates until dry. Then, antibiotic discs (Hangzhou Binhe Microorganism Reagent Co., Ltd., Hangzhou, China) were attached to the medium surface with sterile forceps, and the plates were incubated upside down in a 37 °C incubator for 24 h. After incubation, the diameter of the inhibition zones was measured. LGG and S. aureus were used as control.
2.4.3. Oral Toxicity Analysis of L. plantarum LPJZ-658
Eight- to ten-week-old C57BL/6 mice were purchased from Jilin GENET-MED Biotechnology Co., Ltd. (Jilin, China). The oral toxicity of L. plantarum LPJZ-658 was analyzed as previously described [47]. Briefly, 20 male and 20 female C57BL/6 mice were adaptive feeding for 5 days before the experiment, and then male and female mice were divided into two groups, with 10 males and 10 females in each group, respectively. L. plantarum LPJZ-658 was given by oral gavage once a day at a dose of 1011 CFU/day for 14 days. The behavior, death, and poisoning of the mice were observed, and the average weight per mouse was calculated once a day.
2.5. In Vitro Characterization of L. plantarum LPJZ-658
2.5.1. Acid and Bile Salt Tolerance Analysis of L. plantarum LPJZ-658
The acid and bile salt tolerance of L. plantarum LPJZ-658 was detected as previously described with some modification [48]. For acid tolerance of L. plantarum LPJZ-658, the active grown cells were harvested, washed with phosphate-buffered saline (PBS) buffer, and resuspended in an equal volume of MRS broth with pH adjusted to 3.0, and then 100 µL aliquots were obtained at different time intervals (0 h and 3 h) for gradient dilution. Suitable dilutions were selected for inoculation on MRS agar and incubated for 24 h at 37 °C. Colonies were counted and recorded.
Bile tolerance of L. plantarum LPJZ-658 was examined in MRS broth containing 0.3% (w/v) bile salts (Beijing Solarbio Science & Technology Co., Ltd., Beijing, China). Samples were collected at 0 h and 3 h, respectively. Bacteria were serially diluted 10-fold using PBS and inoculated in triplicate onto MRS agar plates. The plates were incubated at 37 °C for 24 h. Colonies were counted and recorded. The above two experiments were repeated three times each, respectively.
2.5.2. Cell Surface Hydrophobicity Analysis of L. plantarum LPJZ-658
Cell surface hydrophobicity of L. plantarum LPJZ-658 was evaluated as the reported method with some modifications [49]. The bacteria were grown in MRS broth at 37 °C for 20 h and then harvested by centrifugation at 1500× g for 20 min. The pellets were washed and resuspended in PBS buffer (pH 7.4) to the optical density (OD600) corresponding to about 108 CFU/mL (A0). Then, an equal volume of xylene was added and incubated at 37 °C for 10 min, and the suspensions were vortexed for 2 min. The two-phase system was incubated at 37 °C for 1 h. The aqueous phase was measured by determining the OD at 600 nm (A1). The percentage of bacterial adhesion to solvent was calculated: [(A1 − A0)/A0] × 100.
2.5.3. Auto-Aggregation Analysis of L. plantarum LPJZ-658
Auto-aggregation analysis of L. plantarum LPJZ-658 was performed, referring to the reported method with some modifications [50]. Bacteria cultures were grown at 37 °C in MRS broth for 20 h. Bacteria were then harvested by centrifugation, washed two times, and resuspended in PBS buffer. The initial concentration of L. plantarum LPJZ-658 was adjusted to OD600 to obtain a viable bacterial count (A0) of approximately 108 CFU/mL. Absorbance (At) was then measured using the same method after 24 h of incubation at 37 °C. The auto-aggregation percentage was expressed as: [(At − A0)/A0] × 100.
2.5.4. Antibacterial Activity
The inhibitory effects of L. plantarum LPJZ-658 against common bacterial pathogens, such as E. coli BNCC269342, S. typhimurium BNCC333565, and S. aureus BNCC310011 were measured using the Oxford cup diffusion method [51] with LGG strain as control. E. coli, S. typhimurium, and S. aureus were incubated in LB medium at 37 °C for 18 h. Bacterial pathogens suspension was diluted to 108 cfu/mL, and 0.2 mL of each diluted pathogens suspension was inoculated on LB plates and evenly with a sterile cotton swab, creating a vertical Oxford cup on each equidistant plate. Then, 200 μL of triple concentrated L. plantarum LPJZ-658 or LGG culture supernatant was added to the hole, respectively. Distilled water was chosen as the control. Each strain had three replicates. The plates were then incubated for 24 h at 37 °C. The antimicrobial function of L. plantarum LPJZ-658 was determined by measuring the diameter of the circular antimicrobial zone.
2.6. Statistical Analysis
Paired t-tests were performed on all data using GraphPad Prism 7. Data are expressed as means ± standard error of the mean (SEM), and p-values of <0.05 were considered significant.
3. Results
3.1. Genome Characteristics of L. plantarum LPJZ-658
The genome sequencing (Table 1) indicated that the whole genome of L. plantarum LPJZ-658 comprised 3.26 Mbp (3,259,902 bp), with an average GC content of 44.83%, encoding a total of 3254 ORFs. The total length of all encoded genes was 2,733,840 bp, and the average length of encoded genes was 840 bp, containing 100 Tandem Repeat (TR) sequences with a total length of 20,760 bp, including 78 Minisatellite DNAs with a total length of 9131 bp, and 1 Microsatellite DNA with a total length of 39 bp, 69 tRNA genes, 10 5S rRNAs, 5 16S rRNAs and 23S rRNAs, and 1 sRNA. The genome sequencing data for L. plantarum LPJZ-658 has been submitted to GenBank (no. SRR22306760), and the L. plantarum LPJZ-658 genome map is shown in Figure 1A.
Table 1.
Main genome characteristic of L. plantarum LPJZ-658.
Figure 1.
Genome features of L. plantarum LPJZ-658. (A) Genomic map of L. plantarum LPJZ-658. From the outer circle to the inner circle: the first circle is the distribution of the coding genes. The second is the COG annotated genes. The third is the KEGG annotated genes. The fourth is the GO annotated genes. The fifth circle is the distribution of ncRNA. (B) The amino acid sequence of L. plantarum LPJZ-658 annotation based on the COG database. The left side shows the distribution of the number of COG functions analyzed on the annotations. The horizontal coordinates are the COG function categories. Different characters and colors correspond to different types on the right side, and the vertical coordinates are the number of genes. (C) The amino acid sequence of L. plantarum LPJZ-658 annotation based on the KEGG database. The number on the bar chart indicates the number of genes on the annotation. The other coordinate axis is the code for each level 1 functional class in the database. (D) The amino acid sequence of L. plantarum LPJZ-658 annotation based on the CAZy database. (E) The phylogenetic relationship among selected Lactobacillus strains and L. plantarum LPJZ658 was generated by using the neighbor-joining method based on the 16S rRNA gene sequence.
3.2. Genomic Functional Annotation of L. plantarum LPJZ-658
The genomic functional annotation of L. plantarum LPJZ-658 was predicted based on GO, KEGG, COG, NR, CAZy, T3SS, VFDB, CARD, PHI, ARDB, Swiss-Prot and Pfam databases (blastp, evalue ≤ 1 × 10−5, identity ≥40%, and coverage ≥40%). The final annotation results are shown in Table 2. A total of 4161 genes of the L. plantarum LPJZ-658 genome were annotated. Among them, more genes were functionally annotated in NR, Swiss-Prot, KEGG, COG, GO, and Pfam databases, with 3189, 1255, 3106, 2359, 2211, and 2211 genes, respectively and accounting for 98%, 38.56%, 95.45%, 72.49%, 67.94%, and 67.94% of the total genes, respectively. Notably, only one annotated gene was available in the ARDB database, accounting for 0.03% of the total number of genes.
Table 2.
Database distribution of functional gene annotation from the L. plantarum LPJZ-658.
The functional annotation to COG showed that 22 categories were classified. The most numerous clarified COG categories were transcription (244 genes, accounting for 10.34% of the total number of annotated genes), followed by carbohydrate transport and metabolism (240 genes, accounting for 10.17% of the total number of annotated genes), general function prediction (237 genes, accounting for 10.04% of the total number of annotated genes), amino acid transport and metabolism (231 genes, accounting for 9.79% of the total number of annotated genes) (Figure 1B). The results of KEGG annotation showed that a total of 1318 genes corresponding to the KEGG pathway were enriched in 34 metabolic pathways (Figure 1C). Among them, carbohydrate metabolism, membrane transport, and amino acid metabolism were the three most important metabolic pathways. A total of 132 genes encode protein structural domains belonging to the CAZy family of carbohydrates (Figure 1D). Among them, 62 were Glycoside Hydrolases (GH), 40 were Glycosyltransferases (GT), 23 were Carbohydrate- Binding Modules (CBM), 6 were Carbohydrate Esterases (CE), and 1 was Auxiliary Activities (AA).
3.3. Phylogenetic Analysis and Identification of L. plantarum LPJZ-658
The phylogenetic relationships between L. plantarum LPJZ-658 and 19 Lactobacillus strains obtained from GenBank are described as shown in the phylogenetic tree based on 16S rRNA gene sequence analysis. L. plantarum is grouped and distinguishable from other strains of Lactobacillus (Figure 1E). The strain L. plantarum LPJZ-658 isolated in this study clustered together and was monophyletic with L. plantarum JCM 1149, with a bootstrap value of 100%.
3.4. Safety Evaluation of L. plantarum LPJZ-658
3.4.1. Acute Oral Toxicity Study of L. plantarum LPJZ-658 (14 Days Repeated Dose)
All mice were divided into two groups according to gender, and challenged with 1011 CFU/mice of L. plantarum LPJZ-658 for 14 consecutive days. As seen in Table 3, no significant differences were found in the average body weight of mice challenged with L. plantarum LPJZ-658 (p < 0.05). Furthermore, no death or gross pathological findings were observed in mice of either group.
Table 3.
Relative dynamic change of mice challenged with L. plantarum LPJZ-658 for 14 days.
3.4.2. Virulence-Related Genes and Hemolytic Activity of L. plantarum LPJZ-658
Safety evaluation is an important step in screening new probiotic candidates for human and animal applications, although the results of the virulence factors analysis of L. plantarum LPJZ-658 predicted a total of 99 virulence-related factors. However, almost all of these genes showed low similarity, with less than 75% identity (Table S1). The phenotypic analysis further confirmed the hemolytic activity of L. plantarum LPJZ-658 (Figure 2). After 48 h of incubation on Columbia Blood Agar Plat, neither L. plantarum LPJZ-658 nor LGG exhibited hemolysis ability, whereas S. aureus showed significant β-hemolytic activity. All these results indicated L. plantarum LPJZ-658 is non-hemolysis, which is a prerequisite characteristic of probiotics.
Figure 2.
Hemolytic activity of L. plantarum LPJZ-658. As a positive control, S. aureus (A) produced an obvious zone of β-haemolysis L. plantarum LPJZ-658 (B), and LGG (C) showed γ-hemolysis.
3.4.3. Antibiotic Resistance
The antibiotic susceptibility of L. plantarum LPJZ-658 is shown in Table 4. The results demonstrated that L. plantarum LPJZ-658 is sensitive to ampicillin, erythromycin, gentamicin, midecamycin, and streptomycin; moderately resistant to chloramphenicol and clindamycin; and resistant to ciprofloxacin, kanamycin, and norfloxacin. The Antibiotic Resistance Genes analysis of L. plantarum LPJZ-658 was performed using CARD antibiotic resistance gene databases with identity >75%. Only one antibiotic-resistance gene was identified (Table S2).
Table 4.
Antibiotic susceptibility of L. plantarum LPJZ-658 to antibiotics.
3.5. Functionality Tests as Potential Probiotics of L. plantarum LPJZ-658
3.5.1. Tolerance of L. plantarum LPJZ-658 to Acidic Conditions and Bile Salts
The effect of the simulated harsh gastrointestinal environment on the potential of L. plantarum LPJZ-658 in comparison to LGG is shown in Table 5. The survival of L. plantarum LPJZ-658 was found to be ≥90% after 3 h exposure to acidic conditions (pH 3.0) and 0.3% bile salt solution. Additionally, L. plantarum LPJZ-658 exhibited no significant differences compared to LGG in both acidic conditions and bile salt solution. Genomic features explaining the observed bile tolerance were identified in the bile saline hydrolase (BSH) genome of L. plantarum LPJZ-658 (70.4% identity).
Table 5.
The survival of L. plantarum LPJZ-658 in simulated gastrointestinal conditions.
3.5.2. Cell Surface Hydrophobicity of L. plantarum LPJZ-658
Hydrophobicity and auto-aggregation are important indicators for probiotics adherence to the intestine. As seen in Table 6, after 24 h of incubation, the hydrophobicity capacity of L. plantarum LPJZ-658 and LGG was 33.50% and 28.04%, respectively. Additionally, the auto-aggregation capacity of L. plantarum LPJZ-658 and LGG was 62.59% and 52.32%, respectively. Interestingly, the percentages of hydrophobicity and auto-aggregation of L. plantarum LPJZ-658 were significantly higher than those of LGG.
Table 6.
Cell surface hydrophobicity of L. plantarum LPJZ-658.
3.5.3. Antibacterial Activity
One of the important characteristics of probiotics is to antagonize pathogens. In the current study, the antibacterial activity of L. plantarum LPJZ-658 was evaluated against Gram-positive (S. aureus) and Gram-negative (S. typhimurium and E. coli) pathogenic bacteria. The L. plantarum LPJZ-658 exhibited excellent antagonistic activity against the tested bacteria, in which the inhibition spectrum of E. coli and S. typhimurium were significantly better than that of LGG (Table 7), and among these, L. plantarum LPJZ-658 showed the strongest antibacterial ability. In order to determine if L. plantarum LPJZ-658 is capable of producing secondary metabolites, the online tool antiSMASH was used to screen the L. plantarum LPJZ-658 genome for secondary metabolite biosynthetic gene clusters. The results showed that a secondary metabolite gene cluster consisting of 51 genes was predicted in the genome of L. plantarum LPJZ-658. All 51 genes encode proteins belonging to type III PKS (T3PKS) (Figure 3). All these results indicated L. plantarum LPJZ-658 own good probiotic properties.
Table 7.
Antibacterial Activity of L. plantarum LPJZ-658.
Figure 3.
A statistical plot of secondary metabolic gene clusters and the number of corresponding genes of L. plantarum LPJZ-658.
4. Discussion
In this study, a new probiotic named L. plantarum LPJZ-658 has been isolated and characterized. The application of whole-genome sequencing-based safety analysis is critical to the development of the probiotic industry. Probiotic bacteria belonging to Lactiplantibacillus plantarum generally have several properties that can be predicted by the presence of the corresponding genes. These are, in particular, genes involved in the synthesis of bacteriocins [52], metabolism [53], conjugation of unsaturated fatty acids [54], production of biologically active peptides [55], and genes encoding exopolysaccharides [56]. In addition, genome-based safety analysis may help to identify potential risk factors for candidate probiotics. However, it should be knowledge that environmental conditions are closely related to gene expression. Therefore, the safety analysis of genomes only theoretically reveals the risk level of probiotics.
To verify the safety of L. plantarum LPJZ-658, the hemolytic activity was tested, and it was reported that probiotics should not have hemolytic properties, especially β-hemolysis, which is considered harmful [57]. Furthermore, it is recommended to assess the hemolytic activity of probiotics used in food products, even if they are generally recognized as safe (GRAS) [58,59]. In our study, L. plantarum LPJZ-658 exhibits γ-hemolysis. Additionally, in the process of safety evaluation of probiotics, resistance assessment is one of the important criteria for strain screening. The resistance of probiotics is mainly intrinsic and acquired. The intrinsic resistance developed during the formation of microorganisms is not usually transferred. Contrarily, if the strain has acquired resistance, it has the risk of transferring virulence genes into the intestine [60]. Therefore, it is necessary to study the distribution of antibiotic-resistance genes in probiotics and the antibiotic resistance pattern of strains [61]. Similar to commercial probiotic strain LGG, the same resistance gene was identified for L. plantarum LPJZ-658 in the CARD database with coverage >40% and identity >75% [48]. Furthermore, the antibiotic susceptibility of L. plantarum LPJZ-658 was further investigated, and the results indicated that L. plantarum LPJZ-658 was sensitive or intermediate sensitive to seven antibiotics, including ampicillin, erythromycin, gentamicin, midecamycin, streptomycin, chloramphenicol, and clindamycin. In vitro, assessment of virulence traits is a prerequisite for probiotic strain candidates, and in vivo studies in the appropriate animal models are also essential to validate the safety of probiotic strain candidates. Oral toxicity studies were considered to be the standard for testing the safety of bacterial strains [62]. In this study, mice orally gavaged with high concentrations of L. plantarum LPJZ-658 for 14 days showed good health status, and no acute toxicity was detected, which confirms that L. plantarum LPJZ-658 is safe for in vivo application. Additionally, more clinical trials are needed in the future to comprehensively evaluate the safety of L. plantarum LPJZ-658.
In order to bring out the health benefits of LPJZ-658, probiotic potential has been further investigated. Tolerance to low-acidic gastric and bile-rich intestinal conditions is one of the prerequisites for probiotic candidate strains due to the extreme conditions that provide a stressful environment for bacteria [63]. The tolerance of probiotic candidate strain to gastrointestinal conditions is normally measured at 3 h after co-culture, as food is transported along the human intestine for up to 3 h [64]. Additionally, bile salts were known to inhibit the growth and multiplication of bacteria, so tolerance to bile salts allows probiotic strains to survive, grow, and function during gastrointestinal transport [65]. In this study, L. plantarum LPJZ-658 maintained high levels of survival in a simulated digestive fluid (pH 3.0 and 0.3% bile salt), which is similar to commercial probiotic LGG. As known, BSH is an enzyme that breaks down bile salts [66]. In addition, BSH is an important enzyme for cholesterol removal, which is associated with cholesterol scavenging ability and is beneficial for people on a high-fat diet [67]. Therefore, bile tolerance in L. plantarum LPJZ-658 may be ascribed to the presence of BSH (identity 70.4%) encoding genes, which could theoretically determine the ability of the strain to tolerate intestinal conditions [68]. It is worth noting that in our previous studies, L. plantarum LPJZ-658 supplementation protects against WD/CCl4-induced non-alcoholic steatohepatitis progression, which is accompanied by alteration of bile acid metabolism profiles. This may be related to the higher BSH activity of LPJZ-658. The ability of probiotics to adhere to the intestine is associated with several types of interactions, including hydrophobicity and auto-aggregation [69]. A prerequisite for being an ideal candidate probiotic is its ability to adhere to epithelial cells and mucosal surfaces. Xylene was chosen as the polar solvent in this study because it reflects the hydrophobicity and hydrophilicity of the cell surface [70], and L. plantarum LPJZ-658 exhibited higher hydrophobicity towards xylene than LGG, indicating good bacterial adhesion of L. plantarum LPJZ-658 to hydrocarbons. These properties are essential for the colonization of probiotic cultures in the gastrointestinal (GI) epithelium to prevent elimination by peristalsis and to play a functional role in intestinal homeostasis [64]. Auto-aggregation is also closely related to cell adhesion to the GI tract, which explains the probiotic properties of the bacteria [71]. The present study revealed that L. plantarum LPJZ-658 had higher cell hydrophobicity and auto-aggregation compared to LGG, indicating its good cell adhesion properties. S. thyphimurium, E. coli, and S. aureus are common intestinal pathogens that are highly susceptible to causing infections in the body, promoting an inflammatory response in the intestinal tract, destroying the intestinal barrier, and causing diarrhea and other diseases [72]. Previous studies had reported the antimicrobial activity of probiotics [73], which in agreement with our study, the L. plantarum LPJZ-658 showed excellent antimicrobial activity against pathogenic bacteria, including S. thyphimurium, E. coli, and S. aureus. The production of antimicrobial substances is one of the important factors in regulating intestinal microecology and maintaining the health of the host. The antimicrobial substances in probiotics include organic acids, hydrogen peroxide, and bacteriocins [74,75]. The intriguing property of L. plantarum LPJZ-658 is the presence of a secondary metabolite gene cluster consisting of 51 genes found in its genome. All of these 51 genes encode proteins belonging to T3PKS. T3PKS is one of the two most abundant biosynthetic gene clusters in all LAB genera [76]. As known, T3PKS are all known to be small dimeric proteins (80–90 kDa) associated with the biosynthesis of polyketides [77]. Polyketides are natural metabolites that comprise the basic chemical structure of antibiotics, antifungals, parasiticides, and immunomodulators [78]. This class of compounds mainly includes polyethers, tetracycles, quinones, macrolides, and other substances with great applications in anti-infective, antitumor, and immunosuppressive applications [79]. It has also been suggested that the specific secondary metabolite T3PKS may be related to bacterial survival and antibacterial activity in the intestinal environment [80,81]. This suggests that L. plantarum LPJZ-658 encoded T3PKS may be correlating with its broad-spectrum antibacterial activity.
5. Conclusions
In this study, the genomic level, safety, and probiotic properties of L. plantarum LPJZ-658 were comprehensively evaluated using in vitro and in vivo methods. All these results indicated that L. plantarum LPJZ-658 has great potential as a probiotic in human and animal applications. This was supported by genome sequencing and other normal probiotic characteristics such as non-hemolytic activity, high survival under acid and bile conditions, high antibiotic susceptibility, good cell adhesion ability, and excellent antimicrobial activity. In addition, no pathogenicity or mortality was observed in oral toxicity studies. Overall, L. plantarum LPJZ-658 is safe and has good probiotic properties, and more studies could be done in the future to clarify the application potential of L. plantarum LPJZ-658 on gastrointestinal health and in the food industry.
Supplementary Materials
The following supporting information can be downloaded at: https://www.mdpi.com/article/10.3390/microorganisms11061620/s1, Table S1: Putative virulence factors in the L. plantarum LPJZ-658 genome by searching with the VFDB; Table S2: Putative antibiotics resistance genes in the L. plantarum LPJZ-658 genome by searching with the CARD.
Author Contributions
Conceptualization: L.D. and L.L.; methodology: L.D. and L.L.; software: T.F. and C.L. (Chunhua Li); formal analysis: H.Z.; investigation: T.F.; resources: H.Z.; data curation: L.D. and L.L.; writing—original draft preparation: L.D. and L.L.; writing—review and editing: C.L. (Chang Li), and Y.L.; supervision: N.J.; project administration: C.Z.; funding acquisition: C.Z. All authors have read and agreed to the published version of the manuscript.
Funding
The current study was supported by the Zhejiang Provincial Natural Science Foundation of China: LGF19H030012.
Institutional Review Board Statement
All animal experiments carried out in this study were approved by the Animal Care and Use Ethics Committee of Jilin Agricultural Science and Technology University (Jilin, China).
Data Availability Statement
Data sharing is not applicable to this article.
Acknowledgments
We want to show our appreciation to Ming Shen and Yu Ding (Jilin Zhongtai Biotechnology Co., Ltd., Jilin, China) for their help in providing data analysis.
Conflicts of Interest
All authors declare that there is no conflict of interest regarding the publication of this study.
References
- Teleky, B.E.; Martau, G.A.; Vodnar, D.C. Physicochemical Effects of Lactobacillus plantarum and Lactobacillus casei Cocultures on Soy-Wheat Flour Dough Fermentation. Foods 2020, 9, 1894. [Google Scholar] [CrossRef]
- Li, K.; Wang, S.; Liu, W.; Kwok, L.Y.; Bilige, M.; Zhang, W. Comparative genomic analysis of 455 Lactiplantibacillus plantarum isolates: Habitat-specific genomes shaped by frequent recombination. Food Microbiol. 2022, 104, 103989. [Google Scholar] [CrossRef] [PubMed]
- Wang, Y.; Xing, X.; Ma, Y.; Fan, Y.; Zhang, Y.; Nan, B.; Li, X.; Wang, Y.; Liu, J. Prevention of High-Fat-Diet-Induced Dyslipidemia by Lactobacillus plantarum LP104 through Mediating Bile Acid Enterohepatic Axis Circulation and Intestinal Flora. J. Agric. Food Chem. 2023, 71, 7334–7347. [Google Scholar] [CrossRef] [PubMed]
- Liu, Z.; Zhao, J.; Sun, R.; Wang, M.; Wang, K.; Li, Y.; Shang, H.; Hou, J.; Jiang, Z. Lactobacillus plantarum 23-1 improves intestinal inflammation and barrier function through the TLR4/NF-kappaB signaling pathway in obese mice. Food Funct. 2022, 13, 5971–5986. [Google Scholar] [CrossRef]
- Yue, Y.; He, Z.; Zhou, Y.; Ross, R.P.; Stanton, C.; Zhao, J.; Zhang, H.; Yang, B.; Chen, W. Lactobacillus plantarum relieves diarrhea caused by enterotoxin-producing Escherichia coli through inflammation modulation and gut microbiota regulation. Food Funct. 2020, 11, 10362–10374. [Google Scholar] [CrossRef]
- Zhou, X.; Zhang, D.; Qi, W.; Hong, T.; Xiong, T.; Wu, T.; Geng, F.; Xie, M.; Nie, S. Exopolysaccharides from Lactobacillus plantarum NCU116 Facilitate Intestinal Homeostasis by Modulating Intestinal Epithelial Regeneration and Microbiota. J. Agric. Food Chem. 2021, 69, 7863–7873. [Google Scholar] [CrossRef]
- Guimaraes, A.; Santiago, A.; Teixeira, J.A.; Venancio, A.; Abrunhosa, L. Anti-aflatoxigenic effect of organic acids produced by Lactobacillus plantarum. Int. J. Food Microbiol. 2018, 264, 31–38. [Google Scholar] [CrossRef] [PubMed]
- Ahire, J.J.; Jakkamsetty, C.; Kashikar, M.S.; Lakshmi, S.G.; Madempudi, R.S. In Vitro Evaluation of Probiotic Properties of Lactobacillus plantarum UBLP40 Isolated from Traditional Indigenous Fermented Food. Probiotics Antimicrob. Proteins 2021, 13, 1413–1424. [Google Scholar] [CrossRef]
- Cortes-Zavaleta, O.; Lopez-Malo, A.; Hernandez-Mendoza, A.; Garcia, H.S. Antifungal activity of lactobacilli and its relationship with 3-phenyllactic acid production. Int. J. Food Microbiol. 2014, 173, 30–35. [Google Scholar] [CrossRef]
- Silva, D.R.; Orlandi Sardi, J.d.C.; Pitangui, N.d.S.; Roque, S.M.; Barbosa da Silva, A.C.; Rosalen, P.L. Probiotics as an alternative antimicrobial therapy: Current reality and future directions. J. Funct. Foods 2020, 73, 104080. [Google Scholar] [CrossRef]
- Nath, S.; Sikidar, J.; Roy, M.; Deb, B. In vitro screening of_probiotic properties of Lactobacillus plantarum isolated from fermented milk product. Food Qual. Saf. Oxf. Acad. 2020, 4, 213–223. [Google Scholar] [CrossRef]
- Liu, D.-M.; Huang, Y.-Y.; Liang, M.-H. Analysis of the probiotic characteristics and adaptability of Lactiplantibacillus plantarum DMDL 9010 to gastrointestinal environment by complete genome sequencing and corresponding phenotypes. Lwt 2022, 158, 113129. [Google Scholar] [CrossRef]
- Liu, Y.; Zheng, S.; Cui, J.; Guo, T.; Zhang, J. Lactiplantibacillus plantarum Y15 alleviate type 2 diabetes in mice via modulating gut microbiota and regulating NF-kappaB and insulin signaling pathway. Br. J. Microbiol. 2022, 53, 935–945. [Google Scholar] [CrossRef]
- Yang, X.; Liu, Y.; Guo, X.; Bai, Q.; Zhu, X.; Ren, H.; Chen, Q.; Yue, T.; Long, F. Antiallergic activity of Lactobacillus plantarum against peanut allergy in a Balb/c mouse model. Food Agric. Immunol. 2019, 30, 762–773. [Google Scholar] [CrossRef]
- Yunes, R.A.; Poluektova, E.U.; Vasileva, E.V.; Odorskaya, M.V.; Marsova, M.V.; Kovalev, G.I.; Danilenko, V.N. A Multi-strain Potential Probiotic Formulation of GABA-Producing Lactobacillus plantarum 90sk and Bifidobacterium adolescentis 150 with Antidepressant Effects. Probiotics Antimicrob. Proteins 2020, 12, 973–979. [Google Scholar] [CrossRef] [PubMed]
- Song, X.; Zhao, Z.; Zhao, Y.; Wang, Z.; Wang, C.; Yang, G.; Li, S. Lactobacillus plantarum DP189 prevents cognitive dysfunction in D-galactose/AlCl(3) induced mouse model of Alzheimer′s disease via modulating gut microbiota and PI3K/Akt/GSK-3beta signaling pathway. Nutr. Neurosci. 2022, 25, 2588–2600. [Google Scholar] [CrossRef] [PubMed]
- Liu, Y.W.; Liu, W.H.; Wu, C.C.; Juan, Y.C.; Wu, Y.C.; Tsai, H.P.; Wang, S.; Tsai, Y.C. Psychotropic effects of Lactobacillus plantarum PS128 in early life-stressed and naive adult mice. Brain Res. 2016, 1631, 1–12. [Google Scholar] [CrossRef]
- Hill, C.; Guarner, F.; Reid, G.; Gibson, G.R.; Merenstein, D.J.; Pot, B.; Morelli, L.; Canani, R.B.; Flint, H.J.; Salminen, S.; et al. Expert consensus document. The International Scientific Association for Probiotics and Prebiotics consensus statement on the scope and appropriate use of the term probiotic. Nat. Rev. Gastroenterol. Hepatol. 2014, 11, 506–514. [Google Scholar] [CrossRef]
- Gibson, G.R.; Hutkins, R.; Sanders, M.E.; Prescott, S.L.; Reimer, R.A.; Salminen, S.J.; Scott, K.; Stanton, C.; Swanson, K.S.; Cani, P.D.; et al. The International Scientific Association for Probiotics and Prebiotics (ISAPP) consensus statement on the definition and scope of prebiotics. Nat. Rev. Gastroenterol. Hepatol. 2017, 14, 491–502. [Google Scholar] [CrossRef]
- Guidelines for the Evaluation Of Probiotics in Food; FAO: Paris, France, 2022; pp. 1–11.
- Sanders, M.E.; Akkermans, L.M.; Haller, D.; Hammerman, C.; Heimbach, J.; Hormannsperger, G.; Huys, G.; Levy, D.D.; Lutgendorff, F.; Mack, D.; et al. Safety assessment of probiotics for human use. Gut Microbes 2010, 1, 164–185. [Google Scholar] [CrossRef]
- Li, R.; Zhu, H.; Ruan, J.; Qian, W.; Fang, X.; Shi, Z.; Li, Y.; Li, S.; Shan, G.; Kristiansen, K.; et al. De novo assembly of human genomes with massively parallel short read sequencing. Genome Res. 2010, 20, 265–272. [Google Scholar] [CrossRef]
- Besemer, J.; Lomsadze, A.; Borodovsky, M. GeneMarkS: A self-training method for prediction of gene starts in microbial genomes. Implications for finding sequence motifs in regulatory regions. Nucleic Acids Res. 2001, 29, 2607–2618. [Google Scholar] [CrossRef]
- Saha, S.; Bridges, S.; Magbanua, Z.V.; Peterson, D.G. Empirical comparison of ab initio repeat finding programs. Nucleic Acids Res. 2008, 36, 2284–2294. [Google Scholar] [CrossRef]
- Benson, G. Tandem repeats finder: A program to analyze DNA sequences. Nucleic Acids Res. 1999, 27, 573–580. [Google Scholar] [CrossRef] [PubMed]
- Lowe, T.M.; Eddy, S.R. tRNAscan-SE: A program for improved detection of transfer RNA genes in genomic sequence. Nucleic Acids Res. 1997, 25, 955–964. [Google Scholar] [CrossRef] [PubMed]
- Lagesen, K.; Hallin, P.; Rodland, E.A.; Staerfeldt, H.H.; Rognes, T.; Ussery, D.W. RNAmmer: Consistent and rapid annotation of ribosomal RNA genes. Nucleic Acids Res. 2007, 35, 3100–3108. [Google Scholar] [CrossRef]
- Gardner, P.P.; Daub, J.; Tate, J.G.; Nawrocki, E.P.; Kolbe, D.L.; Lindgreen, S.; Wilkinson, A.C.; Finn, R.D.; Griffiths-Jones, S.; Eddy, S.R.; et al. Rfam: Updates to the RNA families database. Nucleic Acids Res. 2009, 37, D136–D140. [Google Scholar] [CrossRef] [PubMed]
- Nawrocki, E.P.; Kolbe, D.L.; Eddy, S.R. Infernal 1.0: Inference of RNA alignments. Bioinformatics 2009, 25, 1335–1337. [Google Scholar] [CrossRef] [PubMed]
- Kanehisa, M.; Goto, S.; Kawashima, S.; Okuno, Y.; Hattori, M. The KEGG resource for deciphering the genome. Nucleic Acids Res. 2004, 32, D277–D280. [Google Scholar] [CrossRef]
- Ashburner, M.; Ball, C.A.; Blake, J.A.; Botstein, D.; Butler, H.; Cherry, J.M.; Davis, A.P.; Dolinski, K.; Dwight, S.S.; Eppig, J.T.; et al. Gene ontology: Tool for the unification of biology. The Gene Ontology Consortium. Nat. Genet. 2000, 25, 25–29. [Google Scholar] [CrossRef]
- Zhou, Y.; Liang, Y.; Lynch, K.H.; Dennis, J.J.; Wishart, D.S. PHAST: A fast phage search tool. Nucleic Acids Res. 2011, 39, W347–W352. [Google Scholar] [CrossRef]
- Grissa, I.; Vergnaud, G.; Pourcel, C. CRISPRFinder: A web tool to identify clustered regularly interspaced short palindromic repeats. Nucleic Acids Res. 2007, 35, W52–W57. [Google Scholar] [CrossRef] [PubMed]
- Hsiao, W.; Wan, I.; Jones, S.J.; Brinkman, F.S. IslandPath: Aiding detection of genomic islands in prokaryotes. Bioinformatics 2003, 19, 418–420. [Google Scholar] [CrossRef] [PubMed]
- Kanehisa, M.; Goto, S.; Hattori, M.; Aoki-Kinoshita, K.F.; Itoh, M.; Kawashima, S.; Katayama, T.; Araki, M.; Hirakawa, M. From genomics to chemical genomics: New developments in KEGG. Nucleic Acids Res. 2006, 34, D354–D357. [Google Scholar] [CrossRef]
- Galperin, M.Y.; Makarova, K.S.; Wolf, Y.I.; Koonin, E.V. Expanded microbial genome coverage and improved protein family annotation in the COG database. Nucleic Acids Res. 2015, 43, D261–D269. [Google Scholar] [CrossRef] [PubMed]
- Saier, M.H., Jr.; Reddy, V.S.; Tamang, D.G.; Vastermark, A. The transporter classification database. Nucleic Acids Res. 2014, 42, D251–D258. [Google Scholar] [CrossRef]
- Bairoch, A.; Apweiler, R. The SWISS-PROT protein sequence database and its supplement TrEMBL in 2000. Nucleic Acids Res. 2000, 28, 45–48. [Google Scholar] [CrossRef]
- Cantarel, B.L.; Coutinho, P.M.; Rancurel, C.; Bernard, T.; Lombard, V.; Henrissat, B. The Carbohydrate-Active EnZymes database (CAZy): An expert resource for Glycogenomics. Nucleic Acids Res. 2009, 37, D233–D238. [Google Scholar] [CrossRef]
- Medema, M.H.; Blin, K.; Cimermancic, P.; de Jager, V.; Zakrzewski, P.; Fischbach, M.A.; Weber, T.; Takano, E.; Breitling, R. antiSMASH: Rapid identification, annotation and analysis of secondary metabolite biosynthesis gene clusters in bacterial and fungal genome sequences. Nucleic Acids Res. 2011, 39, W339–W346. [Google Scholar] [CrossRef]
- Eichinger, V.; Nussbaumer, T.; Platzer, A.; Jehl, M.A.; Arnold, R.; Rattei, T. EffectiveDB--updates and novel features for a better annotation of bacterial secreted proteins and Type III, IV, VI secretion systems. Nucleic Acids Res. 2016, 44, D669–D674. [Google Scholar] [CrossRef]
- Petersen, T.N.; Brunak, S.; von Heijne, G.; Nielsen, H. SignalP 4.0: Discriminating signal peptides from transmembrane regions. Nat. Methods 2011, 8, 785–786. [Google Scholar] [CrossRef] [PubMed]
- Urban, M.; Pant, R.; Raghunath, A.; Irvine, A.G.; Pedro, H.; Hammond-Kosack, K.E. The Pathogen-Host Interactions database (PHI-base): Additions and future developments. Nucleic Acids Res. 2015, 43, D645–D655. [Google Scholar] [CrossRef] [PubMed]
- Rajab, S.; Tabandeh, F.; Shahraky, M.K.; Alahyaribeik, S. The effect of lactobacillus cell size on its probiotic characteristics. Anaerobe 2020, 62, 102103. [Google Scholar] [CrossRef] [PubMed]
- Zulkhairi Amin, F.A.; Sabri, S.; Ismail, M.; Chan, K.W.; Ismail, N.; Mohd Esa, N.; Mohd Lila, M.A.; Zawawi, N. Probiotic Properties of Bacillus Strains Isolated from Stingless Bee (Heterotrigona itama) Honey Collected across Malaysia. Int. J. Environ. Res. Public. Health 2019, 17, 278. [Google Scholar] [CrossRef]
- Humphries, R.; Bobenchik, A.M.; Hindler, J.A.; Schuetz, A.N. Overview of Changes to the Clinical and Laboratory Standards Institute Performance Standards for Antimicrobial Susceptibility Testing, M100, 31st Edition. J. Clin. Microbiol. 2021, 59, e00213-21. [Google Scholar] [CrossRef]
- Lu, H.; Zhao, W.; Liu, W.H.; Sun, T.; Lou, H.; Wei, T.; Hung, W.L.; Chen, Q. Safety Evaluation of Bifidobacterium lactis BL-99 and Lacticaseibacillus paracasei K56 and ET-22 in vitro and in vivo. Front. Microbiol. 2021, 12, 686541. [Google Scholar] [CrossRef]
- Zhao, L.; Zhang, Y.; Liu, Y.; Zhong, J.; Zhang, D. Assessing the Safety and Probiotic Characteristics of Lacticaseibacillus rhamnosus X253 via Complete Genome and Phenotype Analysis. Microorganisms 2023, 11, 140. [Google Scholar] [CrossRef]
- Fanelli, F.; Montemurro, M.; Verni, M.; Garbetta, A.; Bavaro, A.R.; Chieffi, D.; Cho, G.S.; Franz, C.; Rizzello, C.G.; Fusco, V. Probiotic Potential and Safety Assessment of Type Strains of Weissella and Periweissella Species. Microbiol. Spectr. 2023, 11, e0304722. [Google Scholar] [CrossRef]
- Kim, Y.; Choi, S.I.; Jeong, Y.; Kang, C.H. Evaluation of Safety and Probiotic Potential of Enterococcus faecalis MG5206 and Enterococcus faecium MG5232 Isolated from Kimchi, a Korean Fermented Cabbage. Microorganisms 2022, 10, 2070. [Google Scholar] [CrossRef] [PubMed]
- Liang, W.; Li, H.; Zhou, H.; Wang, M.; Zhao, X.; Sun, X.; Li, C.; Zhang, X. Effects of Taraxacum and Astragalus extracts combined with probiotic Bacillus subtilis and Lactobacillus on Escherichia coli-infected broiler chickens. Poult. Sci. 2021, 100, 101007. [Google Scholar] [CrossRef] [PubMed]
- Ismael, M.; Wang, T.; Yue, F.; Cui, Y.; Yantin, Q.; Qayyum, N.; Lu, X. A comparison of mining methods to extract novel bacteriocins from Lactiplantibacillus plantarum NWAFU-BIO-BS29. Anal. Biochem. 2023, 661, 114938. [Google Scholar] [CrossRef]
- Sun, C.; Qiu, C.; Zhang, Y.; Yan, M.; Tan, J.; He, J.; Yang, D.; Wang, D.; Wu, L. Lactiplantibacillus plantarum NKK20 Alleviates High-Fat-Diet-Induced Nonalcoholic Fatty Liver Disease in Mice through Regulating Bile Acid Anabolism. Molecules 2023, 28, 4042. [Google Scholar] [CrossRef] [PubMed]
- Liu, X.X.; Zhang, H.Y.; Song, X.; Yang, Y.; Xiong, Z.Q.; Xia, Y.J.; Ai, L.Z. Reasons for the differences in biotransformation of conjugated linoleic acid by Lactobacillus plantarum. J. Dairy Sci. 2021, 104, 11466–11473. [Google Scholar] [CrossRef] [PubMed]
- Tenea, G.N.; Ortega, C. Genome Characterization of Lactiplantibacillus plantarum Strain UTNGt2 Originated from Theobroma grandiflorum (White Cacao) of Ecuadorian Amazon: Antimicrobial Peptides from Safety to Potential Applications. Antibiotics 2021, 10, 383. [Google Scholar] [CrossRef] [PubMed]
- Kudo, H.; Miyanaga, K.; Yamamoto, N. Immunomodulatory effects of extracellular glyceraldehyde 3-phosphate dehydrogenase of exopolysaccharide-producing Lactiplantibacillus plantarum JCM 1149. Food Funct. 2023, 14, 489–499. [Google Scholar] [CrossRef]
- Shin, H.J.; Choi, H.J.; Kim, D.W.; Ahn, C.S.; Lee, Y.G.; Jeong, Y.K.; Joo, W.H. Probiotic Potential of Pediococcus pentosaceus BCNU 9070. J. Life Sci. 2012, 22, 1194–1200. [Google Scholar] [CrossRef]
- Rychen, G.; Aquilina, G.; Azimonti, G.; Bampidis, V.; Bastos, M.d.L.; Bories, G.; Chesson, A.; Cocconcelli, P.S.; Flachowsky, G.; Gropp, J.; et al. Guidance on the characterisation of microorganisms used as feed additives or as production organisms. Efsa J. 2018, 16, e05206. [Google Scholar] [CrossRef]
- Rychen, G.A.G.; Azimonti, G.; Bampidis, V.; Bastos, M.d.L.; Bories, G.; Chesson, A.; Cocconcelli, P.S. EFSA Panel on Additives and Products; Substances Used in Animal Feed. EFSA J. 2022, 20, e07268. [Google Scholar]
- Holzapfel, W.; Arini, A.; Aeschbacher, M.; Coppolecchia, R.; Pot, B. Enterococcus faecium SF68 as a model for efficacy and safety evaluation of pharmaceutical probiotics. Benef. Microbes 2018, 9, 375–388. [Google Scholar] [CrossRef]
- Das, D.J.; Shankar, A.; Johnson, J.B.; Thomas, S. Critical insights into antibiotic resistance transferability in probiotic Lactobacillus. Nutrition 2020, 69, 110567. [Google Scholar] [CrossRef]
- Khalkhali, S.; Mojgani, N. In vitro and in vivo safety analysis of Enterococcus faecium 2C isolated from human breast milk. Microb. Pathog. 2018, 116, 73–77. [Google Scholar] [CrossRef] [PubMed]
- Jena, P.K.; Trivedi, D.; Thakore, K.; Chaudhary, H.; Giri, S.S.; Seshadri, S. Isolation and characterization of probiotic properties of Lactobacilli isolated from rat fecal microbiota. Microbiol. Immunol. 2013, 57, 407–416. [Google Scholar] [CrossRef]
- Begum, S.B.; Roobia, R.R.; Karthikeyan, M.; Murugappan, R.M. Validation of nutraceutical properties of honey and probiotic potential of its innate microflora. Lwt-Food Sci. Technol. 2015, 60, 743–750. [Google Scholar] [CrossRef]
- Argyri, A.A.; Zoumpopoulou, G.; Karatzas, K.A.; Tsakalidou, E.; Nychas, G.J.; Panagou, E.Z.; Tassou, C.C. Selection of potential probiotic lactic acid bacteria from fermented olives by in vitro tests. Food Microbiol. 2013, 33, 282–291. [Google Scholar] [CrossRef] [PubMed]
- Xiong, Z.Q.; Wang, Q.H.; Kong, L.H.; Song, X.; Wang, G.Q.; Xia, Y.J.; Zhang, H.; Sun, Y.; Ai, L.Z. Short communication: Improving the activity of bile salt hydrolases in Lactobacillus casei based on in silico molecular docking and heterologous expression. J. Dairy Sci. 2017, 100, 975–980. [Google Scholar] [CrossRef]
- Dong, Z.; Zhang, J.; Lee, B.; Li, H.; Du, G.; Chen, J. A bile salt hydrolase gene of Lactobacillus plantarum BBE7 with high cholesterol-removing activity. Eur. Food Res. Technol. 2012, 235, 419–427. [Google Scholar] [CrossRef]
- Begley, M.; Hill, C.; Gahan, C.G. Bile salt hydrolase activity in probiotics. Appl. Environ. Microbiol. 2006, 72, 1729–1738. [Google Scholar] [CrossRef]
- Darmastuti, A.; Hasan, P.N.; Wikandari, R.; Utami, T.; Rahayu, E.S.; Suroto, D.A. Adhesion Properties of Lactobacillus plantarum Dad-13 and Lactobacillus plantarum Mut-7 on Sprague Dawley Rat Intestine. Microorganisms 2021, 9, 336. [Google Scholar] [CrossRef]
- Collado, M.C.; Meriluoto, J.; Salminen, S. Measurement of aggregation properties between probiotics and pathogens: In vitro evaluation of different methods. J. Microbiol. Methods 2007, 71, 71–74. [Google Scholar] [CrossRef]
- Kos, B.; Suskovic, J.; Vukovic, S.; Simpraga, M.; Frece, J.; Matosic, S. Adhesion and aggregation ability of probiotic strain Lactobacillus acidophilus M92. J. Appl. Microbiol. 2003, 94, 981–987. [Google Scholar] [CrossRef]
- Bu, Y.; Liu, Y.; Liu, Y.; Wang, S.; Liu, Q.; Hao, H.; Yi, H. Screening and Probiotic Potential Evaluation of Bacteriocin-Producing Lactiplantibacillus plantarum In Vitro. Foods 2022, 11, 1575. [Google Scholar] [CrossRef]
- Pajor, M.; Worobo, R.W.; Milewski, S.; Szweda, P. The Antimicrobial Potential of Bacteria Isolated from Honey Samples Produced in the Apiaries Located in Pomeranian Voivodeship in Northern Poland. Int. J. Environ. Res. Public. Health 2018, 15, 2002. [Google Scholar] [CrossRef]
- Fijan, S. Probiotics and Their Antimicrobial Effect. Microorganisms 2023, 11, 528. [Google Scholar] [CrossRef] [PubMed]
- Egan, K.; Field, D.; Rea, M.C.; Ross, R.P.; Hill, C.; Cotter, P.D. Bacteriocins: Novel Solutions to Age Old Spore-Related Problems? Front. Microbiol. 2016, 7, 461. [Google Scholar] [CrossRef]
- Mileriene, J.; Aksomaitiene, J.; Kondrotiene, K.; Asledottir, T.; Vegarud, G.E.; Serniene, L.; Malakauskas, M. Whole-Genome Sequence of Lactococcus lactis Subsp. lactis LL16 Confirms Safety, Probiotic Potential, and Reveals Functional Traits. Microorganisms 2023, 11, 1034. [Google Scholar] [CrossRef]
- Shimizu, Y.; Ogata, H.; Goto, S. Discriminating the reaction types of plant type III polyketide synthases. Bioinformatics 2017, 33, 1937–1943. [Google Scholar] [CrossRef] [PubMed]
- Staunton, J.; Weissman, K.J. Polyketide biosynthesis: A millennium review. Nat. Prod. Rep. 2001, 18, 380–416. [Google Scholar] [CrossRef] [PubMed]
- Tae, H.; Sohng, J.K.; Park, K. MapsiDB: An integrated web data- base for type I polyketide synthase. Bioprocess Biosyst. Eng. 2009, 32, 723–727. [Google Scholar] [CrossRef]
- Zhu, W.Z.; Wang, S.H.; Gao, H.M.; Ge, Y.M.; Dai, J.; Zhang, X.L.; Yang, Q. Characterization of Bioactivities and Biosynthesis of Angucycline/Angucyclinone Derivatives Derived from Gephyromycinifex aptenodytis gen. nov., sp. nov. Mar. Drugs 2021, 20, 34. [Google Scholar] [CrossRef]
- Somashekaraiah, R.; Mottawea, W.; Gunduraj, A.; Joshi, U.; Hammami, R.; Sreenivasa, M.Y. Probiotic and Antifungal Attributes of Levilactobacillus brevis MYSN105, Isolated From an Indian Traditional Fermented Food Pozha. Front. Microbiol. 2021, 12, 696267. [Google Scholar] [CrossRef]
Disclaimer/Publisher’s Note: The statements, opinions and data contained in all publications are solely those of the individual author(s) and contributor(s) and not of MDPI and/or the editor(s). MDPI and/or the editor(s) disclaim responsibility for any injury to people or property resulting from any ideas, methods, instructions or products referred to in the content. |
© 2023 by the authors. Licensee MDPI, Basel, Switzerland. This article is an open access article distributed under the terms and conditions of the Creative Commons Attribution (CC BY) license (https://creativecommons.org/licenses/by/4.0/).